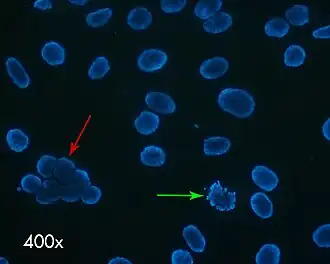

Catástrofe mitótica
La catástrofe mitótica se definió en 2012 por el Comité de Nomenclatura sobre Muerte Celular como un mecanismo intrínseco que detecta los fallos en la mitosis y responde conduciendo a la célula a un estado irreversible antiproliferativo de muerte o senescencia.[1] Después de fallar la activación del punto o puntos de control de G2/M, las células con lesiones en el DNA (o replicación incorrecta) activan un programa apoptótico que lleva a la manifestación fenotípica de la catástrofe mitótica.[2]
La catástrofe mitótica es un acontecimiento en el que una célula es destruida durante la mitosis. Algunos creen que ocurre como resultado de un intento de una segregación aberrante de los cromosomas en etapas tempranas de la mitosis, o como resultado de un daño posterior del DNA.
El término "catástrofe mitótica" se utiliza para explicar un mecanismo de muerte celular retrasada ligada a mitosis, una serie de acontecimientos que resultan de una entrada prematura o inapropiada de las células en el proceso de mitosis que puede ser causado por estrés físico o químico. Puede ser desencadenado con agentes que influyan en la estabilidad de los microtúbulos, varios fármacos anticancerígenos y fallos mitóticos causados por puntos de control del ciclo celular defectuosos. La catástrofe mitótica es la forma principal de muerte de célula inducida por radiación ionizante.
Es frecuente que las células que no consiguen realizar una catástrofe mitótica tras un fallo mitótico creen células aneuploides cuando se dividen posteriormente, planteando un riesgo de oncogénesis que llevarán potencialmente a un cáncer.
Referencias
- ↑ Mc Gee, Margaret M. (27 de septiembre de 2015). «Targeting the Mitotic Catastrophe Signaling Pathway in Cancer». Mediators of Inflammation (en inglés) 2015: 1-13. PMC 4600505. PMID 26491220. doi:10.1155/2015/146282. Consultado el 19 de noviembre de 2015.
- ↑ Castedo, Maria; Perfettini, Jean-Luc; Roumier, Thomas; Andreau, Karine; Medema, Rene; Kroemer, Guido (1 de enero de 2004). «Cell death by mitotic catastrophe: a molecular definition». Oncogene (en inglés) 23 (16): 2825-2837. ISSN 0950-9232. doi:10.1038/sj.onc.1207528. Consultado el 19 de noviembre de 2015.
Bibliografía
Chow, J.P.H. Y Poon, R.Y.C. (2010) catástrofe Mitótica. Desregulación de Ciclo de la célula en Cáncer p.79-96. Ed. Greg Enders. Salmer, Nueva York.
Vakifahmetoglu H, Olsson M, Zhivotovsky B. Muerte a través de una tragedia: catástrofe mitótica. Muerte de célula Difiere 2008; 15: 1153@–1162. url = http://www.apo-sys.eu/aposys/publications/publications2008-pdf/vakifahmetoglu-tragedy.pdf (enlace roto disponible en Internet Archive; véase el historial, la primera versión y la última).